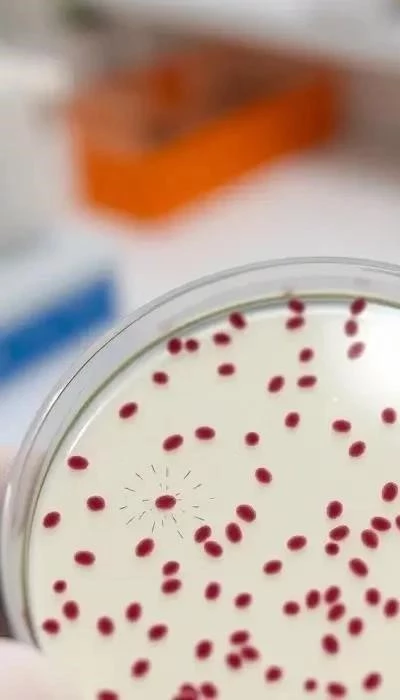

Хламидиоз – это распространенная инфекция, вызываемая бактерией Chlamydia trachomatis, которая часто протекает бессимптомно, особенно у женщин. В 2026 году, несмотря на достижения в медицине, хламидиоз остается актуальной проблемой общественного здравоохранения из-за риска серьезных осложнений. Инфекция передается преимущественно половым путем, но возможен и бытовой путь (через загрязненные предметы обихода, при контакте с инфицированными слизистыми оболочками глаз, ротовой полости и заднего прохода). Инкубационный период может варьироваться от нескольких дней до нескольких недель.
Важно помнить: хламидиоз опасен не только своим зачастую скрытым течением, но и потенциальными долгосрочными последствиями для репродуктивной системы. У мужчин проявляется в виде уретрита (воспаление мочеиспускательного канала) с выделениями и дискомфортом при мочеиспускании. У женщин инфекция может поражать шейку матки, вызывая цервицит, а также распространяться на мочевой пузырь и фаллопиевы трубы, приводя к воспалительным заболеваниям органов малого таза.
Современные методы диагностики включают полимеразную цепную реакцию (ПЦР), иммуноферментный анализ (ИФА) и посев. Для подтверждения диагноза необходимо сдать анализы из уретры (у мужчин), шейки матки (у женщин) и, при необходимости, из других очагов инфекции. Лечение в 2026 году основывается на применении антибиотиков, рекомендованных Всемирной организацией здравоохранения (ВОЗ), с учетом чувствительности возбудителя. Обязательно лечение обоих половых партнеров для предотвращения повторного заражения.
Профилактика хламидиоза включает использование барьерной контрацепции (презервативов), регулярные обследования, особенно при смене половых партнеров, и отказ от случайных половых связей. Укрепление иммунитета и своевременное лечение сопутствующих инфекций также играют важную роль в предотвращении заражения. Помните, раннее выявление и лечение хламидиоза – залог сохранения здоровья и предотвращения серьезных осложнений.
Что такое хламидиоз: Общая информация и пути передачи
Хламидиоз – это инфекционное заболевание, вызываемое бактерией Chlamydia trachomatis. Эта бактерия является облигатным внутриклеточным паразитом, то есть способна размножаться только внутри клеток человека. Хламидии поражают слизистые оболочки, вызывая воспаление. В 2026 году хламидиоз остается одной из самых распространенных инфекций, передающихся половым путем (ИППП), хотя встречается и вне половой сферы.
Пути передачи хламидиоза преимущественно связаны с сексуальным контактом – вагинальным, анальным или оральным. Инфицирование возможно даже при отсутствии эякуляции. Реже, но все же возможно, заражение бытовым путем – через загрязненные предметы обихода (полотенца, белье), особенно при контакте с инфицированными слизистыми оболочками глаз или ротовой полости. Вертикальный путь передачи – от матери к ребенку во время родов – также представляет серьезную опасность.

Инкубационный период хламидиоза может варьироваться от 5 до 60 дней, в среднем – около 2-3 недель. Особенностью хламидиоза является его частое бессимптомное течение, особенно у женщин. Это связано с особенностями иммунного ответа организма и способностью бактерии скрываться внутри клеток. Бессимптомное течение является основной причиной поздней диагностики и распространения инфекции, а также развития серьезных осложнений, таких как воспалительные заболевания органов малого таза (ВЗОМТ) у женщин и бесплодие у обоих полов.
Важно понимать, что даже при отсутствии видимых симптомов, инфицированный человек может быть источником заражения для других. Поэтому регулярные обследования и своевременное лечение имеют решающее значение для предотвращения распространения хламидиоза и сохранения репродуктивного здоровья. Хламидиоз – это не просто «неудобство», а серьезная инфекция, требующая внимания и ответственного подхода.

Симптомы хламидиоза у женщин: Особенности и возможные осложнения
Симптомы хламидиоза у женщин часто бывают слабо выражены или вовсе отсутствуют, что затрудняет своевременную диагностику. При поражении шейки матки могут наблюдаться скудные, прозрачные или желтоватые выделения из влагалища, зуд и дискомфорт после полового акта. В некоторых случаях возможно появление небольших кровотечений между менструациями. Воспаление мочевого пузыря (цистит) проявляется частыми позывами к мочеиспусканию, болью и жжением при мочеиспускании.
При распространении инфекции на фаллопиевы трубы развивается сальпингит – воспаление, которое может привести к образованию спаек и непроходимости труб. Это состояние сопровождается болью внизу живота, повышением температуры тела и общим недомоганием. Хронический хламидиоз может протекать практически бессимптомно, но при этом постепенно повреждать репродуктивные органы.
Возможные осложнения хламидиоза у женщин крайне серьезны. Воспалительные заболевания органов малого таза (ВЗОМТ) могут привести к хроническим болям в области таза, нарушению менструального цикла и, самое опасное, к бесплодию. Внематочная беременность – еще одно серьезное осложнение, связанное с непроходимостью фаллопиевых труб. Кроме того, хламидиоз может повысить риск заражения ВИЧ и других ИППП. Важно помнить, что даже при отсутствии явных симптомов, хламидиоз может нанести непоправимый вред репродуктивному здоровью женщины.
Регулярные гинекологические осмотры и своевременное проведение анализов на хламидиоз – это ключевые меры профилактики и раннего выявления инфекции. При появлении любых подозрительных симптомов необходимо немедленно обратиться к врачу для диагностики и лечения.
Симптомы хламидиоза у мужчин: Проявления и риски для здоровья
Симптомы хламидиоза у мужчин часто проявляются в виде уретрита – воспаления мочеиспускательного канала. Наиболее распространенным признаком являются выделения из уретры, которые могут быть слизистыми, гнойными или водянистыми. В начале заболевания выделения могут быть обильными, но постепенно становятся скудными, наблюдаясь преимущественно по утрам. Сопутствующими симптомами являются зуд и жжение при мочеиспускании, а также покраснение и отек наружного отверстия мочеиспускательного канала.
В некоторых случаях хламидиоз может распространяться на простату, вызывая простатит. Простатит проявляется болью в области промежности, поясницы и мошонки, а также нарушением мочеиспускания. Также возможно развитие эпидидимита – воспаления придатка яичка, которое сопровождается болью, отеком и покраснением мошонки. Хронический хламидиоз у мужчин может протекать бессимптомно или с периодическими обострениями.
Риски для здоровья, связанные с хламидиозом у мужчин, включают развитие бесплодия. Воспаление мочеиспускательного канала и придатка яичка может привести к образованию спаек и непроходимости семявыносящих путей, что препятствует нормальному продвижению сперматозоидов. Кроме того, хламидиоз может повысить риск развития реактивного артрита – воспаления суставов, которое возникает в ответ на инфекцию. Важно помнить, что своевременное лечение хламидиоза необходимо для предотвращения серьезных осложнений и сохранения репродуктивной функции.
Регулярные медицинские осмотры и обследования, особенно при смене половых партнеров, помогут выявить хламидиоз на ранней стадии и предотвратить его распространение. При появлении любых подозрительных симптомов необходимо немедленно обратиться к врачу.
Диагностика хламидиоза: Современные методы и необходимые анализы
Диагностика хламидиоза в 2026 году располагает широким спектром современных и высокоточных методов. Наиболее распространенным и чувствительным методом является полимеразная цепная реакция (ПЦР). ПЦР позволяет обнаружить ДНК возбудителя даже при низкой концентрации, что особенно важно на ранних стадиях инфекции или при бессимптомном течении. Для ПЦР-диагностики используются соскобы из уретры (у мужчин) или шейки матки (у женщин), а также моча.
Другим распространенным методом является иммуноферментный анализ (ИФА). ИФА позволяет обнаружить антитела к хламидиям в крови. Однако, ИФА менее специфичен, чем ПЦР, и может давать ложноположительные результаты при наличии других инфекций. Посев на питательную среду также используется для диагностики хламидиоза, но он менее чувствителен и требует больше времени для получения результатов.
Необходимые анализы для подтверждения диагноза хламидиоза включают: ПЦР-диагностику соскобов из уретры (у мужчин) и шейки матки (у женщин), а также анализ мочи. В некоторых случаях может потребоваться проведение ИФА для определения стадии инфекции и оценки эффективности лечения. Важно, что для получения достоверных результатов необходимо соблюдать правила сбора биоматериала и проводить анализы в аккредитованных лабораториях. Рекомендуется сдать анализы обоим половым партнерам, даже если у одного из них нет симптомов.
Современные методы диагностики позволяют выявлять хламидиоз на ранней стадии, что значительно повышает эффективность лечения и предотвращает развитие осложнений. Своевременное обращение к врачу и проведение необходимых анализов – залог сохранения здоровья и предотвращения распространения инфекции.
Лечение и профилактика хламидиоза: Комплексный подход в 2026 году
Лечение хламидиоза в 2026 году основывается на применении антибиотиков, выбор которых зависит от чувствительности возбудителя и клинической картины заболевания. Согласно рекомендациям ВОЗ, препаратами первой линии являются азитромицин и докцициклин. Азитромицин обычно назначается однократно в высокой дозе, а доксициклин – курсом в течение 7-10 дней. Важно, что лечение должно быть назначено врачом после проведения необходимых анализов и определения чувствительности хламидий к антибиотикам.
Обязательным условием успешного лечения является одновременное лечение обоих половых партнеров, даже если у одного из них нет симптомов. Это необходимо для предотвращения повторного заражения и развития хронической формы инфекции. Возможные побочные эффекты от лечения антибиотиками могут включать тошноту, рвоту, диарею и аллергические реакции. В случае возникновения побочных эффектов необходимо обратиться к врачу.
Профилактика хламидиоза включает комплекс мер, направленных на предотвращение заражения и распространения инфекции. Основными мерами профилактики являются использование барьерной контрацепции (презервативов) при каждом половом контакте, регулярные обследования на наличие ИППП, особенно при смене половых партнеров, и отказ от случайных половых связей. Важно соблюдать правила личной гигиены и избегать контакта с потенциально инфицированными предметами.
Комплексный подход к лечению и профилактике хламидиоза включает не только медикаментозную терапию, но и укрепление иммунитета, лечение сопутствующих инфекций и ведение здорового образа жизни. Своевременное обращение к врачу и соблюдение всех рекомендаций специалиста – залог успешного лечения и предотвращения осложнений.
